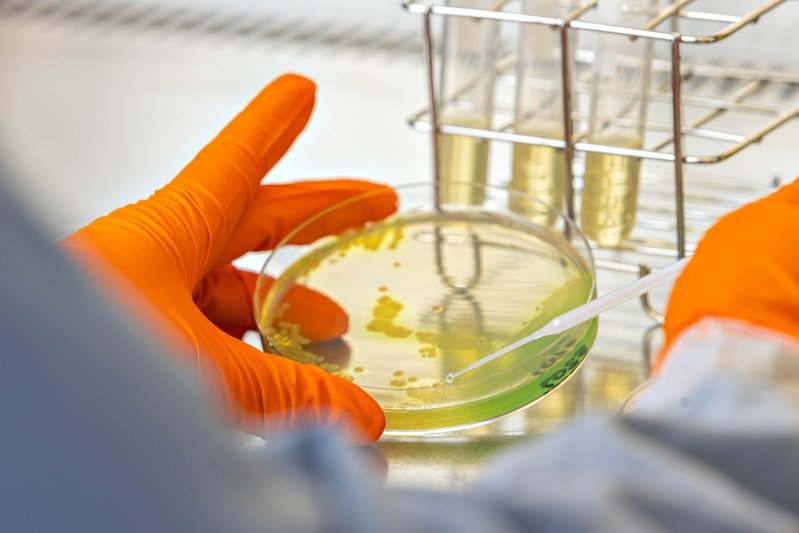
© Antabio / Franck Sonnet

© Antabio / Franck Sonnet
Cet article est réservé à nos abonnés. 95% reste à lire
Pour accéder à cet article, à l'ensemble du site ainsi qu'à nos bases de données, découvrez nos formules d'abonnement.
Accès intégral gratuit - Sans engagement
© Antabio / Franck Sonnet
Pour accéder à cet article, à l'ensemble du site ainsi qu'à nos bases de données, découvrez nos formules d'abonnement.









